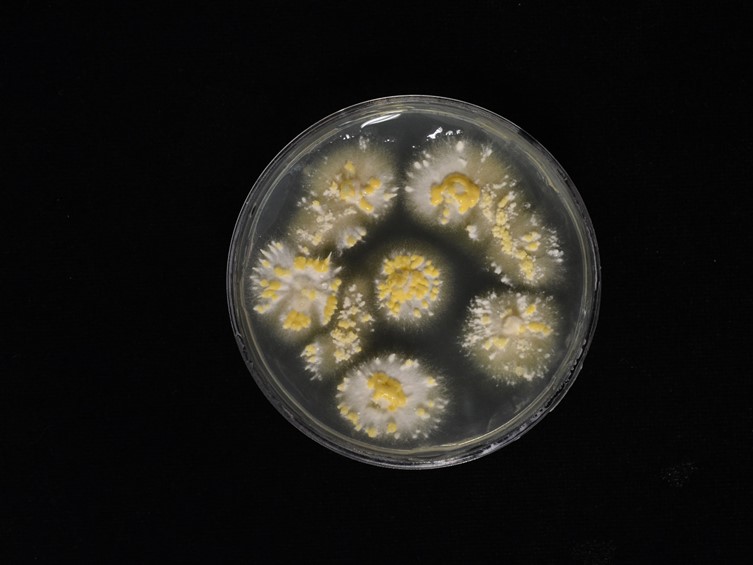

Holotype:
THAILAND, Phitsanulok Province, Noen Maprang district, 27 Jun. 2017, S. Lamlertthon, S. Mongkolsamrit, K. Tasanathai, W. Noisripoom, holotype BBH 42883, ex-type living culture BCC 84553.
Habitat:
Buried in the soil.
Host:
Coleoptera larva.
Description:
 Stroma numerous, 0.5-2.5 mm in length, 1-1.5 mm in breadth, cylindrical, reddish brown. Rhizoids flexuous, arising from the head of Coleoptera larva, ca 1-3.5 cm long under the ground. Fertile part hemispherical perithecial plates, some terminal, many subterminal, pale yellowish brown, 0.5-4 mm diam, 1-2 mm high.
Stroma numerous, 0.5-2.5 mm in length, 1-1.5 mm in breadth, cylindrical, reddish brown. Rhizoids flexuous, arising from the head of Coleoptera larva, ca 1-3.5 cm long under the ground. Fertile part hemispherical perithecial plates, some terminal, many subterminal, pale yellowish brown, 0.5-4 mm diam, 1-2 mm high.  Perithecia ovoid with protruding apices, 900-1 100 × 350-450 μm.
Perithecia ovoid with protruding apices, 900-1 100 × 350-450 μm.  Asci cylindrical, 300-700 × 3-5 μm.
Asci cylindrical, 300-700 × 3-5 μm.  Ascospores hyaline, filiform, cylindrical, breaking into small truncate part-spores, 3-6 × 1-1.5 μm.
Ascospores hyaline, filiform, cylindrical, breaking into small truncate part-spores, 3-6 × 1-1.5 μm.
Culture characteristics:
Colonies on PDA moderately growing, ca 1 cm diam in 7 d at 25°C, white, cottony and with abundant mycelial density. Synnemata forming after 21 d, solitary, unbranched, up to 2 mm long. Conidial mass produced on subterminal part of synnemata or covering the surface of colony. Two types of phialides present: α-phialides consisting of verticillate branches with phialides in whorls of 2–5. Entire phialides 7–22 × 1–2 μm, with cylindrical basal portion, α-conidia fusoid to globose, 2–3 × 1.5–2 μm, in conidial masses on PDA. β-phialides consisting of erect conidiophores either arising from aerial or vegetative hyphae. Phialides solitary along the hyphae. Entire phialides 12–25 × 2–2.5 μm, awl-shaped, β-conidia fusiform, in chains, 3–8 × 1–2.5 μm.
Colonies on PDA moderately growing, ca 1 cm diam in 7 d at 25°C, white, cottony and with abundant mycelial density. Synnemata forming after 21 d, solitary, unbranched, up to 2 mm long. Conidial mass produced on subterminal part of synnemata or covering the surface of colony. Two types of phialides present: α-phialides consisting of verticillate branches with phialides in whorls of 2–5. Entire phialides 7–22 × 1–2 μm, with cylindrical basal portion, α-conidia fusoid to globose, 2–3 × 1.5–2 μm, in conidial masses on PDA. β-phialides consisting of erect conidiophores either arising from aerial or vegetative hyphae. Phialides solitary along the hyphae. Entire phialides 12–25 × 2–2.5 μm, awl-shaped, β-conidia fusiform, in chains, 3–8 × 1–2.5 μm.
Reference:
Crous PW, Wingfield MJ, Burgess TI, et al. (2017). Fungal Planet description sheets. Persoonia 39: 270–467.
DOI: https://doi.org/10.3767/persoonia.2017.39.11Species |
Strain |
Compound |
Pubchem CID |
Biological activity |
Reference |
|---|
|
Strain |
ITS | LSU | RPB1 | TEF1 |
|---|---|---|---|---|
| BCC 84551 | MF959731 | MF959735 | MF959743 | MF959739 |
| BCC 84552 | MF959732 | MF959736 | MF959744 | MF959740 |
| BCC 84553 | MF959733 | MF959737 | MF959745 | MF959742 |
| BCC 84557 | MF959734 | MF959738 | MF959746 | MF959741 |